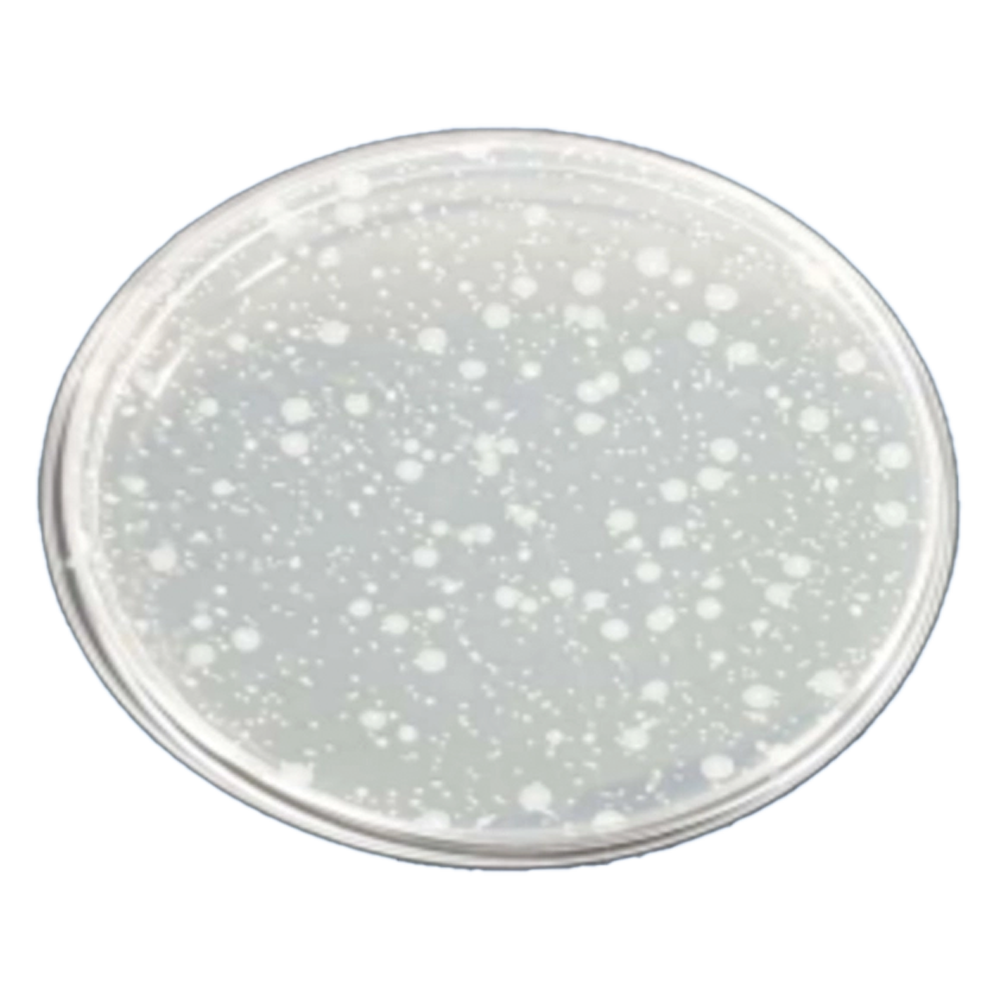
0517대장균_일반LED
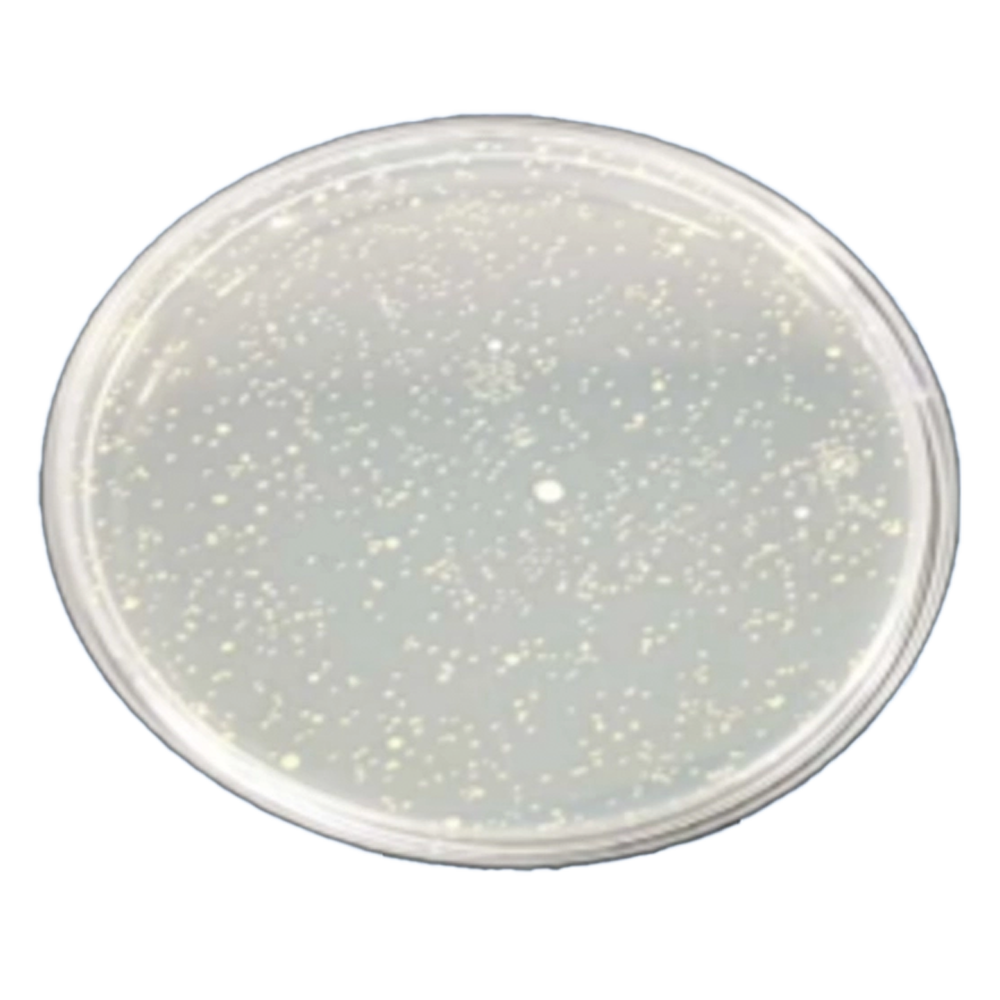
바실러스균_일반LED

Model | MTC-BB-10W |
|---|---|
Power | 10W |
LED Package | SMD 2835, 3030 |
Material | Aluminum + Plastic |
IP Rating | IP55 |
Lamp Size (mm) | A60(60*60) |
Correlated Color Temperature | 3000K, 5700K |
Beam Angle (º) | 200º |
Operating Voltage | 180V ~ 265Vac |
Warranty Period | 1 Year |
Rated Voltage | 220V |
Power Factor (PF) | ≥ 0.9 |
Operating Temperature | -25ºC ~ -45ºC |
Compliance Standards | KC, CE |
Application Areas | Indoor, Outdoor |


Model | MTC-B6D-15W |
|---|---|
Power | 15W |
LED Package | SMD 2835, 3030 |
Material | Metal + Plastic |
IP Rating | IP45 |
Lamp Size (mm) | 152 * 152 |
Correlated Color Temperature | 3000K, 5700K |
Beam Angle (º) | 120º |
Operating Voltage | 180V ~ 265Vac |
Warranty Period | 1 Year |
Rated Voltage | 220V |
Power Factor (PF) | ≥ 0.9 |
Operating Temperature | -25ºC ~ -45ºC |
Compliance Standards | KC, CE |
Application Areas | Indoor, Outdoor |


Model | Anti-bacterial LED Bar |
|---|---|
Correlated Color Temperature | 3000K, 5700K |
Input Voltage (V) | 220 |
Input Current (A) | 0.014 |
Power Consumption (W) | 3 |
Power Factor (PF) | >= 0.9 |
Total Luminous Flux (lm) | 210 |
Luminous Efficacy (lm/W) | 70 |
Color Rendering Index (Ra) | >= 90 |
Special Features of MTC Antimicrobial Technology
Unlike other LED products with a Color Rendering Index (CRI) of around 70RA to 80RA, which is similar to sunlight at 70% to 80%, our antimicrobial LED product is 98% similar to sunlight. There is no need to worry about eye damage caused by blue light wavelengths. It provides a more powerful antimicrobial function across all color temperatures. The MTC light has been tested by a certified testing institution in South Korea to verify its ability to destroy bacteria 2m away from the light source.
Comparison with Other Products on the Market
Antimicrobial LEDs available in the market
No antimicrobial effect within a 30cm range
Antimicrobial LED function only operates when no one is present; when people are present, it switches to regular LED function
Causes eye damage due to blue light (harmful to humans)
MTC Antimicrobial LED
Complete antimicrobial effect within a 2m range
24-hour operation of LED antimicrobial function with the option to choose any desired lighting color
Eliminates blue light (harmless to humans) to prevent eye damage
| Salmonella bacteria | 0157 E. coli | Bacillus bacteria | |
|---|---|---|---|
| After 8 hours of regular antimicrobial LED lighting | ![]() | ![]() | ![]() |
| After 8 hours of MTC Antimicrobial LED lighting | ![]() | ![]() | ![]() |
MTC LED maintains a temperature of 3000K to 6500K, similar to sunlight, while destroying all bacterial molecules.

Regular antimicrobial LED light spectrum

MTC Antimicrobial LED light spectrum
Antibacterial LED Effect
7 Key Benefits of Infrared Rays Beneficial to the Human Body
Antibacterial and Water Purification Effect
Skin Regeneration and Beauty Effect
Moisture Retention
Maintaining Optimal Body Temperature
Maintaining Nutritional Balance
Waste Disposal and Fatigue Recovery
Various Effects of Antibacterial Lighting
Elimination of Pet Odors in Dog Owners' Homes
Reduction of Ammonia Odor in Pig Farms
Bacteria Eradication and Deodorization Effect in Bathrooms
Reduction of Salmonella Bacteria in Poultry Farms to Prevent Mass Deaths of Chickens
Promotion of Plant Growth with a Rich Spectrum
Key Features of Antibacterial LED Lighting
No Flickering
Eye Protection
Uniform Light
Energy Saving
High Brightness
Waterproof
Long Usage Time